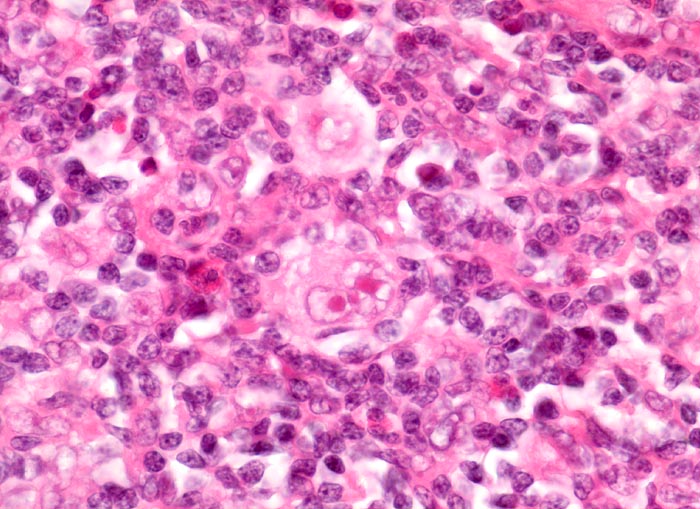

PathoPic – image database / PathoPic ID 3911 - Hodgkin-Lymphom, noduläre Sklerose: Reed-Sternberg Zelle
de
Diagnose
Hodgkin-Lymphom, noduläre Sklerose: Reed-Sternberg Zelle
Diagnose Gruppe
maligner Tumor
Topographie
Lymphknoten, mediastinal
Topographie Gruppe
Lymphatische Gewebe, KM, Milz
Beschreibung
In der Bildmitte eine Reed-Sternbergzelle mit spiegelbildlich angeordneten Kernen mit sehr prominenten eosinophilen Nukleolen. Die Tumorzelle ist umgeben von einem reaktiven gemischtzelligen Infiltrat. Oberhalb der Reed-Sternbergzelle eine einkernige neoplastische Hodgkinzelle umgeben von einem schmalen Spaltraum.
Klinik
Mediastinaler Tumorbulk.
Bilder Typ
Histologie
Vergrösserung
630
Alter
21
Geschlecht
unbekannt
Datum
Ersteintrag: 28.09.2002